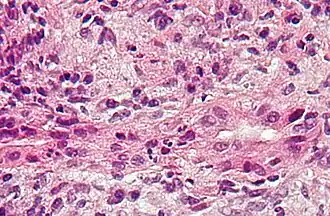

Hepatopatía
| Hepatopatía | ||
|---|---|---|
![]() | ||
| Especialidad | Gastroenterología | |
| Tipos | Hígado graso, Hepatitis (y otras) | |
| Diagnóstico | Tests de función hepática | |
| Tratamiento | Depende del tipo (Véase tipos) | |
| Sinónimos | ||
| Enfermedad hepática | ||
La hepatopatía es un tipo de lesión o enfermedad del hígado. Cuando la lesión es duradera, aparece la hepatopatía crónica.
Signos y síntomas
Algunos de los signos y síntomas de la hepatopatía son los siguientes:
- Ictericia.
- Confusión y consciencia alterada causada por encefalopatía hepática.
- Trombocitopenia y coagulopatía.[1]
- Riesgo de síntomas de hemorragia particularmente en el tracto gastrointestinal.[2]
- Ascitis, acumulación de líquido en la cavidad abdominal.
Causa

Existen más de cien tipos diferentes de hepatopatías. Estas son algunas de las más comunes:[3]
- Fascioliasis, una infección parásita del hígado causado por una duela hepática del género Fasciola, mayoritariamente el Fasciola hepatica.[4]
- Hepatitis, inflamación del hígado, está causado por varios virus (hepatitis viral), también por algunas toxinas de hígado (p. ej. hepatitis alcohólica), autoinmunidad (hepatitis autoimmune) o factores hereditarios.[5]
- Hepatopatía alcohólica es una manifestación hepática del abuso de alcohol, incluyendo esteatosis hepática, hepatitis alcohólica, y cirrosis. Se usan también términos análogos como hepatopatía inducida por fármacos o tóxica para referirse a las alteraciones causadas por varios fármacos.[5]
- Enfermedad del hígado graso (esteatosis hepática) es una condición reversible donde las vacuolas grandes llenas de triglicéridos se acumulan en células del hígado.[6] El hígado graso no alcohólico es un espectro de la enfermedad asociada con obesidad y síndrome metabólico.[7]
- Enfermedades hereditarias que causan daño al hígado como la hemocromatosis,[8] que implica acumulación de hierro en el cuerpo, y la enfermedad de Wilson. El daño hepático es también una característica clínica de la deficiencia de alfa 1-antitripsina[9] y la enfermedad de almacenamiento de glucógeno tipo II.[10]
- En la amiloidosis hereditaria relacionada con la transtiretina, que se debe a una mutación en el gen de la transtiretina. el hígado produce transtiretina anormal que tiene efectos neurodegenerativos y/o cardiovasculares severos. El tratamiento consiste en el trasplante de hígado.[11]
- El síndrome de Gilbert, un desorden genético del metabolismo de bilirrubina que afecta a un porcentaje pequeño de la población, puede causar ictericia leve.[12]
- La cirrosis es la formación de tejido fibroso (fibrosis) en el sitio de las células hepáticas que han muerto debido a una variedad de causas, incluyendo hepatitis viral, abuso de alcohol y otras formas de toxicidad del hígado. La cirrosis puede causar insuficiencia hepática crónica.[13]
- El cáncer hepático primario generalmente se manifiesta comohepatocarcinoma y/o colangiocarcinoma; las formas más raras incluyen angiosarcoma y hemangiosarcoma hepáticos. (Muchos cánceres hepáticos son lesiones secundarias que han metastatizado de cánceres primarios en el tracto gastrointestinal y otros órganos, como los riñones o los pulmones.)[14]
- La cirrosis biliar primaria es una enfermedad autoinmune severa de los canalículo biliar.[15]
- La colangitis esclerosante primaria es una enfermedad inflamatoria crónica severa de las vías biliares, y se cree que tiene un origen autoinmune.[16]
- El síndrome de Budd–Chiari es un cuadro clínico causado por oclusión de la vena hepática.
Mecanismo
Las hepatopatías pueden ocurrir por varios mecanismos:
Daño al ADN
Un mecanismo general, aumento del daño al ADN, lo comparten varias causas mayores de las hepatopatías. Estas causas mayores incluyen infección por el virus de la hepatitis B o hepatitis C, abuso de alcohol y obesidad.
Las infecciones virales por el virus de la hepatitis B (HBV) o de la hepatitis C (HCV) causan un aumento de las especies reactivas de oxígeno (ROS). El aumento de ROS intracelular es de aproximadamente 10.000 veces con una infección de HBV crónica y de 100.000 veces tras una infección de HCV. Este aumento en ROS causa inflamación, lo que aumenta aún más las ROS. ROS causa más de 20 tipos de Daño al ADN.[17] El daño oxidativo al ADN es mutagénico[18] y puede causar también alteraciones epigenéticas en los sitios de reparación del ADN.[19] Las alteraciones epigenéticas y mutaciones afectan a la maquinaria celular y puede llevar a la célula a replicarse a una mayor velocidad, o a que esta evite la apoptosis, contribuyendo al daño hepático.[20] A medida que acumula mutaciones y cambios epigenéticos, se desarrollará eventualmente un carcinoma hepatocelular, en el que las alteraciones epigenéticas parecen tener un papel más importante en la carcinogénesis que las mutaciones. Solo un gen, TP53, está mutado en más del 20% de los cánceres hepáticos, mientras que 41 genes presentan promotores hipermetilados (reprimiendo la expresión génica) en más del 20% de los cánceres hepáticos.
El consumo del alcohol en exceso causa una acumulación de acetaldehído. El acetaldehído y los radicales libres generados por el metabolismo del alcohol inducen daño al ADN y estrés oxidativo.[21][22][23] Adicionalmente, la activación de neutrófilos en la hepatopatía alcohólica contribuye a la patogénesis del daño hepatocelular liberando ROS (que contribuyen al daño en el ADN).[24] El nivel de estrés oxidativo y el daño al ADN causado por el acetaldehído no parecen suficientes para aumentar la mutagénesis.[24] Sin embargo, revisado por Nishida et al.,[19] la exposición a alcohol, causando daño oxidativo al ADN (que es reparable), puede resultar en alteraciones epigenéticas en los sitios de reparación del ADN. Las alteraciones epigenéticas de la expresión génica inducidas por alcohol parecen conducir a hepatopatías y finalmente a carcinomas.
La obesidad está relacionada con un mayor riesgo de cáncer hepático primario.[25] Como se muestra en ratones, los ratones obesos son propensos a padecer cáncer hepático, principalmente por dos factores. Los ratones obesos tienen aumentadas las citoquinas proinflamatorias. También tienen niveles mayores de ácido desoxicólico (DCA), un producto del ácido biliar producido por cierto microorganismo intestinales, los cuales también están incrementados con obesidad. El exceso de DCA causa daño al ADN e inflamación en el hígado, lo que puede conducir a cáncer hepático.
Otros aspectos relevantes
Una forma común de hepatopatía es la infección viral. Las hepatitis virales como la HBV y la HCV se pueden transmitir verticalmente en el parto por contacto con sangre infectada.[26][27] De acuerdo con una publicación de 2012 del NICE, "aproximadamente el 85% de las infecciones de hepatitis B en neonatos se convierte en crónica".[28] En casos ocultos, se encuentra el ADN del virus de la hepatitis B, pero las pruebas de HBsAg dan negativo.[29] El abuso de alcohol puede llevar a diversas formas de enfermedades hepáticas como la hepatitis alcohólica, el hígado graso alcohólico, cirrosis y cáncer hepático.[30] En las fases tempranas de la hepatopatía alcohólica, la grasa se sintetiza en las células hepáticas mediante el aumento en la síntesis de triglicéridos y ácidos grasos, y la disminución de la capacidad de degradar ácidos grasos. La progresión de la enfermedad puede llevar a inflamación hepática por el exceso de grasa en el hígado. La fibrosis en el hígado ocurre dado que el cuerpo intenta sanar el órgano, y un exceso de cicatrización puede llevar al desarrollo de cirrosis en estados más avanzados de la enfermedad.[31] Aproximadamente 3-10% de los individuos con cirrosis desarrollan una forma de cáncer hepático denominada carcinoma hepatocelular.[24]
De acuerdo con Tilg et al., la microbiota intestinal puede tener un efecto, estar implicada en la patofisiología, en los diversos tipos de enfermedad hepática de cada individuo.
Contaminantes del aire
Las partículas en suspensión (PS) o el carbón negro (CN) son contaminantes comunes. Los siguientes factores son los efectos dañinos de la exposición del hígado a PS o CN. Primero, tienen un evidente efecto tóxico directo sobre el hígado. Los químicos afectan el metabolismo y tienen un impacto en la función hepática. Segundo, la inflamación del hígado causada por PS y CN tienen un impacto sobre el metabolismo de lípidos y el hígado graso. Tercero, las PS y CN se pueden traslocar de los pulmones al hígado.
Las PS y CN pueden traslocarse fácilmente de los pulmones al hígado. Dada su diversidad y sus diferentes toxicodinámicas, los mecanismos detallados no están claros. Las fracciones solubles de PS es la parte más importante para la traslocación de PS al hígado a través de la circulación extrapulmonar. Cuando las PS van a través de los vasos sanguíneos a la sangre, se combinan con las células inminer, que estimulan respuestas inmunes innatas. Se liberan citoquinas proinflamatorias, causando la progresión de la enfermedad.[32]
Diagnóstico
Existe un gran número de test de función hepática (TFH) para comprobar el correcto funcionamiento del hígado. Comprueban la presencia de enzimas en la sangre que normalmente son más abundantes en el tejido hepático: proteínas séricas, albúmina sérica, globulina sérica, alanina transaminasa, aspartato transaminasa, tiempo de protrombina, tiempo de tromboplastina parcial activado.
Los test de imagen como la elastografía transitoria, ultrasonidos e imagen por resonancia magnética se pueden usar para examinar el tejido hepático y los ductos biliares. La biopsia hepática se puede realizar para examinar el tejido hepático y poder distinguir entre diversas alteraciones; los test como la elastografía pueden reducir la necesidad de biopsia en algunas situaciones.
En la hepatopatía, el tiempo de protrombina es más largo de lo habitual.[1] Adicionalmente, la cantidad de factores coagulantes y factores anticoagulantes están reducidos, dado que el hígado no los puede sintetizar productivamente.[24] Sin embargo, existen dos excepciones en esta tendencia, que son el factor de coagulación VIII y el factor de von Willebrand, una proteína plaquetaria adhesiva.[24] Ambos se elevan en el inicio de la insuficiencia hepática, debido a la caída de la limpieza hepática y la producción compensatoria en otras partes del cuerpo.[24] La fibrinolisis generalmente ocurre más rápido en ataques agudos de fallo hepático, así como en estadios avanzados de la hepatopatía en contraste con la hepatopatía crónica, donde la concentración de fibrinógeno permanece constante.[24]
Una hepatopatía previa no diagnosticada se puede detectar tras la autopsia. Abajo se muestran imágenes de la patología:
-
Cirrosis difusa -
Cirrosis macronodular -
Textura de nuez moscada de la hepatopatía congestiva -
Metástasis hepáticas
Tratamiento

La medicación antiviral está enfocada a tratar infecciones como la hepatitis B.[33] Otras condiciones pueden controlarse ralentizando la progresión de la enfermedad, por ejemplo:
- Mediante el uso de medicamentos esteroideos en la hepatitis autoinmune.[34]
- Eliminar regularmente una cantidad de sangre de una vena (venosección) en la condición de sobrecarga de hierro, hemocromatosis .[35]
- La enfermedad de Wilson, una afección en la que el cobre se acumula en el cuerpo, se puede controlar con medicamentos que se unen al cobre, lo que le permite pasar del cuerpo a la orina.[36]
- En la enfermedad hepática colestásica (donde el flujo de bilis se ve afectado debido a la fibrosis quística) se puede administrar un medicamento llamado ácido ursodesoxicólico (URSO, también conocido como UDCA).[37]
Véase también
Referencias
- ↑ a b Blonski, Wojciech; Siropaides, Timothy; Reddy, K. Rajender (2007-12). «Coagulopathy in liver disease». Current Treatment Options in Gastroenterology 10 (6): 464-473. ISSN 1092-8472. PMID 18221607. doi:10.1007/s11938-007-0046-7. Consultado el 10 de febrero de 2020.
- ↑ Tripodi, Armando; Mannucci, Pier Mannuccio (14 de julio de 2011). «The coagulopathy of chronic liver disease». The New England Journal of Medicine 365 (2): 147-156. ISSN 1533-4406. PMID 21751907. doi:10.1056/NEJMra1011170. Consultado el 10 de febrero de 2020.
- ↑ «Liver disease». nhs.uk (en inglés). 19 de octubre de 2017. Consultado el 10 de febrero de 2020.
- ↑ Prevention, CDC-Centers for Disease Control and (16 de abril de 2019). «CDC - Fasciola». www.cdc.gov (en inglés estadounidense). Consultado el 10 de febrero de 2020.
- ↑ a b «Alcoholic liver disease: MedlinePlus Medical Encyclopedia». medlineplus.gov (en inglés). Consultado el 10 de febrero de 2020.
- ↑ «Hepatic steatosis». TheFreeDictionary.com. Consultado el 10 de febrero de 2020.
- ↑ «Non-alcoholic fatty liver disease (NAFLD)». nhs.uk (en inglés). 19 de octubre de 2017. Consultado el 10 de febrero de 2020.
- ↑ «Hemochromatosis». medlineplus.gov. Consultado el 10 de febrero de 2020.
- ↑ «Alpha-1 Antitrypsin Deficiency». medlineplus.gov. Consultado el 10 de febrero de 2020.
- ↑ Leslie, Nancy; Bailey, Laurie (1993). Adam, Margaret P., ed. GeneReviews®. University of Washington, Seattle. Consultado el 10 de febrero de 2020.
- ↑ «Transthyretin amyloidosis». Genetics Home Reference (en inglés). Consultado el 10 de febrero de 2020.
- ↑ «Gilbert syndrome». Genetics Home Références (en inglés). Consultado el 10 de febrero de 2020.
- ↑ «Cirrhosis: MedlinePlus Medical Encyclopedia». medlineplus.gov (en inglés). Consultado el 10 de febrero de 2020.
- ↑ «Liver cancer - hepatocellular carcinoma: MedlinePlus Medical Encyclopedia». medlineplus.gov (en inglés). Consultado el 10 de febrero de 2020.
- ↑ «Primary biliary cirrhosis: MedlinePlus Medical Encyclopedia». medlineplus.gov (en inglés). Consultado el 10 de febrero de 2020.
- ↑ «Sclerosing cholangitis: MedlinePlus Medical Encyclopedia». medlineplus.gov (en inglés). Consultado el 10 de febrero de 2020.
- ↑ Yu, Yang; Cui, Yuxiang; Niedernhofer, Laura J.; Wang, Yinsheng (12 19, 2016). «Occurrence, Biological Consequences, and Human Health Relevance of Oxidative Stress-Induced DNA Damage». Chemical Research in Toxicology 29 (12): 2008-2039. ISSN 1520-5010. PMC 5614522. PMID 27989142. doi:10.1021/acs.chemrestox.6b00265. Consultado el 10 de febrero de 2020.
- ↑ Dizdaroglu, Miral (31 de diciembre de 2012). «Oxidatively induced DNA damage: mechanisms, repair and disease». Cancer Letters 327 (1-2): 26-47. ISSN 1872-7980. PMID 22293091. doi:10.1016/j.canlet.2012.01.016. Consultado el 10 de febrero de 2020.
- ↑ a b Nishida, Naoshi; Kudo, Masatoshi (2013). «Oxidative stress and epigenetic instability in human hepatocarcinogenesis». Digestive Diseases (Basel, Switzerland) 31 (5-6): 447-453. ISSN 1421-9875. PMID 24281019. doi:10.1159/000355243. Consultado el 10 de febrero de 2020.
- ↑ Shibata, Tatsuhiro; Aburatani, Hiroyuki (2014-06). «Exploration of liver cancer genomes». Nature Reviews. Gastroenterology & Hepatology 11 (6): 340-349. ISSN 1759-5053. PMID 24473361. doi:10.1038/nrgastro.2014.6. Consultado el 10 de febrero de 2020.
- ↑ Yu, Hsu-Sheng; Oyama, Tsunehiro; Isse, Toyohi; Kitagawa, Kyoko; Pham, Thi-Thu-Phuong; Tanaka, Masayuki; Kawamoto, Toshihiro (5 de diciembre de 2010). «Formation of acetaldehyde-derived DNA adducts due to alcohol exposure». Chemico-Biological Interactions 188 (3): 367-375. ISSN 1872-7786. PMID 20813101. doi:10.1016/j.cbi.2010.08.005. Consultado el 10 de febrero de 2020.
- ↑ Lee, Sun-Min; Kim-Ha, Jeongsil; Choi, Won-Young; Lee, Jungwoo; Kim, Dawon; Lee, Jinyoung; Choi, Eunji; Kim, Young-Joon (07 2016). «Interplay of genetic and epigenetic alterations in hepatocellular carcinoma». Epigenomics 8 (7): 993-1005. ISSN 1750-192X. PMID 27411963. doi:10.2217/epi-2016-0027. Consultado el 10 de febrero de 2020.
- ↑ «Drinking alcohol causes cancer by 'damaging DNA'». independent (en inglés). Consultado el 10 de febrero de 2020.
- ↑ a b c d e f g Wang, H. Joe; Gao, Bin; Zakhari, Samir; Nagy, Laura E. (21 de agosto de 2012). «Inflammation in alcoholic liver disease». Annual Review of Nutrition 32: 343-368. ISSN 1545-4312. PMC 3670145. PMID 22524187. doi:10.1146/annurev-nutr-072610-145138. Consultado el 10 de febrero de 2020.
- ↑ Aleksandrova, Krasimira; Stelmach-Mardas, Marta; Schlesinger, Sabrina (2016). «Obesity and Liver Cancer». Recent Results in Cancer Research. Fortschritte Der Krebsforschung. Progres Dans Les Recherches Sur Le Cancer 208: 177-198. ISSN 0080-0015. PMID 27909908. doi:10.1007/978-3-319-42542-9_10. Consultado el 10 de febrero de 2020.
- ↑ Benova, Lenka; Mohamoud, Yousra A.; Calvert, Clara; Abu-Raddad, Laith J. (15 de septiembre de 2014). «Vertical transmission of hepatitis C virus: systematic review and meta-analysis». Clinical Infectious Diseases: An Official Publication of the Infectious Diseases Society of America 59 (6): 765-773. ISSN 1537-6591. PMC 4144266. PMID 24928290. doi:10.1093/cid/ciu447. Consultado el 10 de febrero de 2020.
- ↑ Komatsu, Haruki (21 de julio de 2014). «Hepatitis B virus: where do we stand and what is the next step for eradication?». World Journal of Gastroenterology 20 (27): 8998-9016. ISSN 2219-2840. PMC 4112872. PMID 25083074. doi:10.3748/wjg.v20.i27.8998. Consultado el 10 de febrero de 2020.
- ↑ «Overview | Hepatitis B and C testing: people at risk of infection | Guidance | NICE». www.nice.org.uk. Consultado el 10 de febrero de 2020.
- ↑ Samal, Jasmine; Kandpal, Manish; Vivekanandan, Perumal (2012-01). «Molecular mechanisms underlying occult hepatitis B virus infection». Clinical Microbiology Reviews 25 (1): 142-163. ISSN 1098-6618. PMC 3255968. PMID 22232374. doi:10.1128/CMR.00018-11. Consultado el 10 de febrero de 2020.
- ↑ Suk, Ki Tae; Kim, Moon Young; Baik, Soon Koo (28 de septiembre de 2014). «Alcoholic liver disease: treatment». World Journal of Gastroenterology 20 (36): 12934-12944. ISSN 2219-2840. PMC 4177474. PMID 25278689. doi:10.3748/wjg.v20.i36.12934. Consultado el 10 de febrero de 2020.
- ↑ Williams, Jessica A.; Manley, Sharon; Ding, Wen-Xing (28 de septiembre de 2014). «New advances in molecular mechanisms and emerging therapeutic targets in alcoholic liver diseases». World Journal of Gastroenterology 20 (36): 12908-12933. ISSN 2219-2840. PMC 4177473. PMID 25278688. doi:10.3748/wjg.v20.i36.12908. Consultado el 10 de febrero de 2020.
- ↑ Kim, Jong Won; Park, Surim; Lim, Chae Woong; Lee, Kyuhong; Kim, Bumseok (2014-06). «The role of air pollutants in initiating liver disease». Toxicological Research 30 (2): 65-70. ISSN 1976-8257. PMC 4112066. PMID 25071914. doi:10.5487/TR.2014.30.2.065. Consultado el 10 de febrero de 2020.
- ↑ De Clercq, Erik; Férir, Geoffrey; Kaptein, Suzanne; Neyts, Johan (2010-06). «Antiviral treatment of chronic hepatitis B virus (HBV) infections». Viruses 2 (6): 1279-1305. ISSN 1999-4915. PMC 3185710. PMID 21994680. doi:10.3390/v2061279. Consultado el 10 de febrero de 2020.
- ↑ Hirschfield, Gideon M.; Heathcote, Jenny. (2012). Autoimmune hepatitis : a guide for practicing clinicians. Humana Press. ISBN 978-1-60761-569-9. OCLC 768114273. Consultado el 10 de febrero de 2020.
- ↑ «Phleobotic treatment (en inglés)». Archivado desde el original el 29 de marzo de 2016. Consultado el 10 de febrero de 2020.
- ↑ «Wilson Disease | NIDDK». National Institute of Diabetes and Digestive and Kidney Diseases (en inglés estadounidense). Consultado el 10 de febrero de 2020.
- ↑ Cheng, Katharine; Ashby, Deborah; Smyth, Rosalind L. (09 11, 2017). «Ursodeoxycholic acid for cystic fibrosis-related liver disease». The Cochrane Database of Systematic Reviews 9: CD000222. ISSN 1469-493X. PMC 6483662. PMID 28891588. doi:10.1002/14651858.CD000222.pub4. Consultado el 10 de febrero de 2020.
Otra lecturas
- Friedman, Lawrence S.; Keeffe, Emmet B. (3 de agosto de 2011). Handbook of Liver Disease (en inglés). Elsevier Health Sciences. ISBN 978-1455723164.
